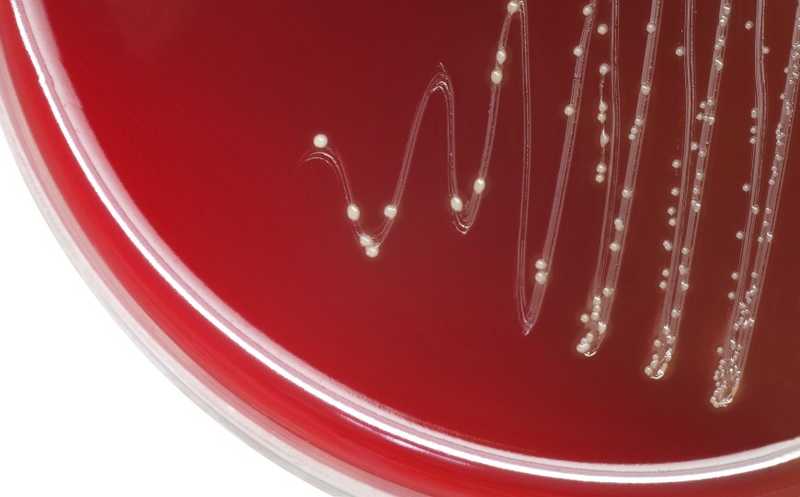

Новый механизм лекарственной устойчивости найден у стрептококка группы А
Австралийские исследователи обнаружили новую форму устойчивости бактерий к противомикробным препаратам, ингибирующим биосинтез фолиевой кислоты, таким как ко-тримоксазол. Устойчивость у стрептококка группы А может быть связана с мутацией, которая делает возможной транспорт тетрагидрофолата из внешней среды и таким образом компенсирует действие антибиотиков.
Группа исследователей во главе с доктором Тимоти Барнеттом, руководителем группы патогенеза и диагностики стрептококка А в Центре вакцин и инфекционных заболеваний Весфармера (Детский институт Телетон, Перт, Западная Австралия) обнаружила новый механизм лекарственной устойчивости (ЛУ).
У стрептококков группы А встречается резистентность к препаратам, ингибирующим синтез фолиевой кислоты в бактериальной клетке. Так, сульфаметоксазол — структурный аналог пара-аминобензойной кислоты, конкурирует с ней за связывание с ферментом, превращающим ПАБК в дигидрофолиевую кисоту, и таким образом ингибирует его синтез. Фолиевая кислота, в свою очередь, необходима для синтеза ДНК. Для лечения распространенных инфекций, включая внебольничный метициллин-резистентный золотистый стафилококк, инфекции мочевыводящих путей, пневмонию и др., сульфаметоксазол используется в комбинации с триметопримом, ингибирующим другой фермент биосинтеза фолатов; комбинация называется ко-тримоксазолом. Известные механизмы устойчивости связаны с мутантными вариантами генов этих ферментов и хорошо идентифицируются тестами на ЛУ.
Авторы новой работы идентифицировали альтернативный механизм — транспортер, который позволяет стрептококку получать из внешней среды тетрагидрофолат и другие подобные соединения. Они определяли минимальные ингибирующие концентрации антибиотиков для коллекционных штаммов стрептококка группы А и обнаружили штаммы, устойчивые к триметоприму, но не к сульфаметоксазолу. Для одного из таких штаммов провели эволюцию in vitro — на чашках с агаром, содержащим градиент ко-тримоксазола, — и получили резистентный к нему изолят.
Сравнение геномов этого изолята и родительского штамма выявило дупликацию длиной в 5 п.н. в промоторном регионе гена thfT, которая повышает его транскрипцию. Белок ThfT гомологичен связывающему субстрат компоненту S транспортера эндогенных фолатов ECF. Авторы предположили, что мутация в промоторном регионе превращает thfT в ген устойчивости: ThfT может «переключить» транспортер на поглощение продуктов, необходимых для биосинтеза фолиевой кислоты, из внешней среды и тем самым позволять бактерии выжить в присутствии антибиотиков.
Действительно, наличие тетрагидрофолата в среде повышало устойчивость новых штаммов к антибиотикам, но не влияло на штамм, не имеющий гена thfT. Методы сравнительной геномики обнаружили в коллекции стрептококка группы А пять штаммов, имеющих ген thfT. Те, которые имели также резистентность к триметоприму, оказались высокорезистентным и к комбинации антибиотиков в присутствии тетрагидрофолата. Авторы также убедились, что тетрагидрофолата в лизате эпителиальных клеток человека достаточно для обеспечения устойчивости. Исследование различных изолятов стрептококка указывает на то, что ген thfT может приобретаться с помощью горизонтального переноса.
«Мы обнаружили механизм резистентности, при котором бактерии впервые продемонстрировали способность получать фолаты непосредственно от человека-хозяина, когда не могут производить свои», — поясняет доктор Барнетт. Против бактерий с такой способностью антибиотик неэффективен, и главное, такую форму устойчивости сложно обнаружить, поскольку для нее еще не существует тестов. Авторы предполагают, что подобные механизмы ЛУ могут существовать и у других бактерий.
Сейчас от инфекций лекарственно-устойчивыми микроорганизмами умирает 1, 27 млн человек ежегодно; ожидается, что к 2050 году они будут уносить 10 миллионов жизней в год, а связанные с этим расходы достигнут 100 триллионов долларов, если не удастся найти радикального решения проблемы. Доктор Барнетт назвал ЛУ «тихой пандемией, представляющей гораздо больший риск для общества, чем COVID-19». Поэтому исследование механизмов устойчивости и разработка методов выявления устойчивых микроорганизмов остаются ключевыми задачами.
Методы тестирования для бактерий с механизмом устойчивости, связанным с thfT, планирует создать первый автор статьи Калинду Родриго; эти экспресс-тесты «можно будет использовать в отдаленных районах, где стрептококковые инфекции группы А являются эндемичными».
Это открытие также объясняет, почему одни и те же изоляты демонстрируют различную ЛУ на разных коммерческих средах: на результат может повлиять даже небольшое количество фолатов в среде.
Источники
M. Kalindu Rodrigo, et al. Host-dependent resistance of Group A Streptococcus to sulfamethoxazolemediated by a horizontally-acquired reduced folate transporter. // Nature Communications, 13, 6557 (2022). DOI: 10.1038/s41467-022-34243-3
Цитаты по пресс-релизу


 Меню
Меню





 Все темы
Все темы




 0
0












